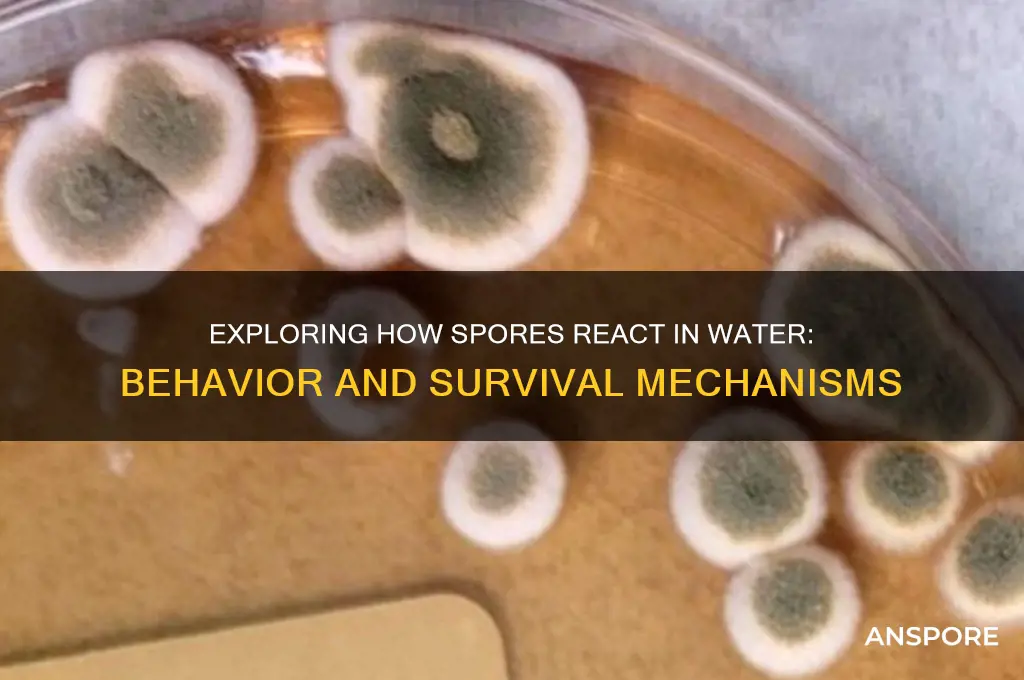
how do spores react in water

Spores, the resilient reproductive structures of various organisms like fungi, bacteria, and plants, exhibit unique behaviors when introduced to water. Their reaction depends on their type and environmental conditions. Some spores, such as those of certain fungi, are hydrophobic and initially repel water, forming a protective barrier to prevent immediate germination. However, prolonged exposure to moisture can trigger metabolic changes, leading to activation and eventual germination. In contrast, bacterial endospores, known for their extreme durability, may remain dormant in water unless specific nutrients or temperature conditions stimulate their revival. Plant spores, like those of ferns or mosses, often require water for dispersal and germination, absorbing moisture to initiate growth. Understanding how spores react in water is crucial for fields like microbiology, ecology, and agriculture, as it influences their survival, dispersal, and role in ecosystems.
| Characteristics | Values |
|---|---|
| Buoyancy | Spores are typically hydrophobic and float on water due to their low density and water-repellent outer layer (exosporium or spore coat). |
| Hydration | Spores can absorb water, but their outer layers resist rapid hydration, allowing them to remain dormant until favorable conditions arise. |
| Germination | Spores generally do not germinate in water alone unless specific triggers (e.g., nutrients, temperature, or pH changes) are present. |
| Dispersal | Water acts as a medium for spore dispersal, especially in aquatic or humid environments, aiding in their spread over large areas. |
| Survival | Spores can survive in water for extended periods due to their resistant structures, protecting them from harsh conditions. |
| Adhesion | Spores may adhere to surfaces in water, facilitated by their hydrophobic nature and surface structures like appendages or coatings. |
| Response to Chemicals | Spores may react to chemicals in water (e.g., salts, nutrients) that can either inhibit or stimulate germination or metabolic activity. |
| Temperature Influence | Water temperature affects spore behavior; warmer temperatures may accelerate germination, while colder temperatures may prolong dormancy. |
| Osmotic Pressure | Spores can tolerate a range of osmotic pressures in water, but extreme conditions may damage or activate them. |
| UV Resistance | Water can shield spores from UV radiation, enhancing their survival in aquatic environments. |
| Metabolic Activity | Spores remain metabolically inactive in water unless specific conditions trigger germination and metabolic resumption. |
| Structural Integrity | Spores maintain their structural integrity in water due to their robust outer layers, preventing immediate degradation. |
Explore related products
What You'll Learn
- Spores' Hydration Mechanisms: How water triggers spore swelling and activation
- Germination Process in Water: Steps spores undergo to transition from dormancy to growth
- Water Temperature Effects: How varying temperatures influence spore viability and response
- Chemical Changes in Water: Impact of water pH and minerals on spore behavior
- Water Pressure Influence: Effects of hydrostatic pressure on spore activation and survival

Spores' Hydration Mechanisms: How water triggers spore swelling and activation
Water acts as a powerful catalyst for dormant spores, initiating a complex cascade of events that culminate in their awakening. This process, known as spore hydration, is a finely tuned mechanism crucial for the survival and propagation of numerous spore-forming organisms, from bacteria to fungi. Upon encountering water, spores undergo a rapid and dramatic transformation, swelling in size as they absorb moisture through specialized structures like the exosporium and spore coat. This initial swelling is not merely a passive process; it's a carefully orchestrated event that triggers a series of biochemical reactions within the spore.
Imagine a tiny, dehydrated seed encased in a protective shell. When exposed to water, the shell softens, allowing water molecules to penetrate and rehydrate the dormant embryo within. Similarly, spores possess intricate structures that regulate water uptake, ensuring a controlled and efficient hydration process.
The key to understanding spore hydration lies in the unique composition of the spore coat and exosporium. These layers, often rich in proteins, lipids, and polysaccharides, act as selective barriers, allowing water molecules to pass through while preventing the entry of larger molecules or potential toxins. This selective permeability is crucial for maintaining the spore's internal environment and protecting its genetic material during the vulnerable reactivation phase.
As water enters the spore, it triggers a series of enzymatic reactions, reactivating metabolic pathways that were dormant during the spore's quiescent state. This metabolic awakening culminates in the synthesis of new proteins and enzymes, ultimately leading to the germination of the spore and the emergence of a new vegetative cell.
Interestingly, the rate and extent of spore hydration are highly species-specific and influenced by various factors, including water availability, temperature, and nutrient presence. For instance, some bacterial spores require a minimum water activity (aw) of 0.90 for germination, while others can germinate at aw values as low as 0.70. Understanding these species-specific requirements is essential for developing effective strategies to control spore-forming pathogens in various environments, from food processing facilities to healthcare settings.
Practical applications of spore hydration mechanisms extend beyond academic curiosity. In the food industry, for example, controlling water activity through techniques like drying, salting, or acidification can effectively prevent spore germination and inhibit the growth of foodborne pathogens. Similarly, in healthcare settings, understanding spore hydration can inform the development of more effective sterilization methods, ensuring the complete eradication of spores from medical equipment and surfaces. By unraveling the intricate mechanisms of spore hydration, we gain valuable insights into the remarkable resilience of these microscopic survivors and develop targeted strategies to control their growth and proliferation in various contexts.
Can Mitosis Produce Spores? Unraveling the Role of Cell Division
You may want to see also

Germination Process in Water: Steps spores undergo to transition from dormancy to growth
Spores, the resilient survival structures of various organisms, undergo a fascinating transformation when introduced to water, initiating a germination process that awakens them from dormancy. This intricate journey involves several distinct steps, each crucial for the spore's transition to active growth.
The Initial Encounter: Hydration and Activation
When spores come into contact with water, the first critical step is hydration. This process is not merely about absorbing moisture; it's a precise mechanism that triggers the spore's internal systems. As water penetrates the spore's protective coat, it activates enzymes and metabolic pathways that have been dormant. For instance, in fungal spores, this hydration phase can lead to the rapid uptake of water, causing the spore to swell and initiating the breakdown of stored nutrients. This initial response is rapid, often occurring within minutes to hours, setting the stage for the subsequent growth phases.
Breaking Dormancy: Metabolic Revival
The next phase is a metabolic awakening. As the spore hydrates, it begins to metabolize stored reserves, primarily lipids and carbohydrates, to fuel its growth. This metabolic revival is a carefully regulated process, ensuring the spore has the energy and resources to support the upcoming developmental changes. In some species, this stage might involve the synthesis of new proteins and enzymes, preparing the spore for the complex tasks of growth and reproduction. For example, in bacterial endospores, hydration triggers the activation of enzymes that break down the spore's protective coat, allowing for the emergence of the vegetative cell.
Emergence and Growth: Unfolding Life
As the spore's metabolism ramps up, it enters a critical growth phase. This stage is characterized by the emergence of the spore's contents, which develop into a new individual. In fungi, this might involve the formation of a germ tube, a structure that extends and develops into a network of hyphae, the building blocks of the fungal body. In plants, such as ferns, spore germination in water leads to the growth of a tiny, heart-shaped structure called a prothallus, which is the initial stage of the plant's life cycle. This emergence process is highly species-specific, with each organism having unique developmental pathways.
Environmental Cues and Optimization
The germination process in water is not just a mechanical response but a finely tuned reaction to environmental cues. Factors like temperature, oxygen availability, and nutrient presence can significantly influence the success and rate of germination. For instance, optimal temperatures for spore germination vary widely; some fungal spores germinate best at 25°C, while certain plant spores may require temperatures above 30°C. Additionally, the presence of specific nutrients in the water can enhance germination rates. Practical applications of this knowledge are seen in agriculture, where controlled environments are used to optimize spore germination for crop production.
Understanding the germination process in water provides valuable insights into the biology of spores and their remarkable ability to transition from dormancy to active life. This knowledge is not only academically intriguing but also has practical implications for various fields, from agriculture and food production to environmental science and medicine. By manipulating the conditions that trigger spore germination, scientists and practitioners can harness the power of these microscopic life forms for numerous beneficial applications.
Milky Spore and Earthworms: Safe or Harmful for Garden Ecosystems?
You may want to see also

Water Temperature Effects: How varying temperatures influence spore viability and response
Spores, the resilient survival structures of various organisms, exhibit a fascinating response to water, particularly when temperature becomes a variable. This critical factor can either awaken dormant spores or render them inactive, depending on the species and the thermal conditions they encounter. Understanding this relationship is essential for fields ranging from microbiology to agriculture, where spore behavior directly impacts outcomes.
Water temperature acts as a switch, controlling the transition between spore dormancy and germination. Generally, spores require specific temperature ranges to activate metabolic processes and initiate growth. For instance, bacterial spores like those of *Bacillus subtilis* often germinate optimally between 30°C and 40°C, while fungal spores, such as those of *Aspergillus niger*, may show peak germination at slightly lower temperatures, around 25°C to 35°C. Outside these ranges, germination rates decline, and extreme temperatures can even destroy spore viability.
Consider the practical implications for food preservation. In canning processes, water baths or pressure cookers heat food to temperatures exceeding 100°C to eliminate bacterial spores, particularly those of *Clostridium botulinum*, which can survive in low-oxygen environments. However, not all spores are equally susceptible to heat. Some thermophilic spores, like those of *Geobacillus stearothermophilus*, require temperatures above 121°C for destruction, necessitating more rigorous sterilization methods. Conversely, in agriculture, understanding optimal germination temperatures for beneficial fungal spores can enhance soil health and crop yields. For example, applying water at 25°C to soil inoculated with *Trichoderma* spores can promote their growth, aiding in plant pathogen suppression.
The relationship between water temperature and spore response is not linear but rather species-specific and influenced by additional factors like pH, nutrient availability, and hydration duration. For instance, while moderate temperatures may activate spores, prolonged exposure to suboptimal temperatures can induce stress responses, delaying or inhibiting germination. Researchers often use controlled temperature experiments to study these dynamics, employing tools like thermal cyclers to simulate environmental conditions. Practical tips for manipulating spore behavior include pre-treating spores with warm water (around 40°C) to accelerate germination in laboratory settings or using cold water (4°C) to store spore suspensions for extended periods without triggering premature activation.
In conclusion, water temperature is a pivotal determinant of spore viability and response, with precise control offering both preservation and activation strategies. Whether in industrial sterilization, agricultural practices, or scientific research, understanding these temperature effects enables more effective management of spore-related processes. By tailoring water temperatures to specific spore requirements, practitioners can optimize outcomes, ensuring safety, efficiency, and productivity across diverse applications.
Do Spores Grow into Mature Fungi? Unveiling the Fungal Life Cycle
You may want to see also
Explore related products
$28.99
$28.99

Chemical Changes in Water: Impact of water pH and minerals on spore behavior
Water pH plays a pivotal role in determining the fate of spores suspended within it. Spores, the resilient dormant forms of certain bacteria, fungi, and plants, exhibit varying behaviors in response to pH levels. Acidic conditions, typically below pH 4, can denature spore proteins and disrupt their protective coat, rendering them more susceptible to environmental stressors. For instance, *Bacillus subtilis* spores show significantly reduced viability in water with a pH of 3 compared to neutral conditions. Conversely, alkaline environments above pH 9 can also impair spore integrity, though the mechanism often involves mineral solubility changes rather than direct protein denaturation. Understanding these pH thresholds is crucial for applications like water treatment and food preservation, where controlling spore survival is essential.
Mineral content in water acts as a silent orchestrator of spore behavior, often interacting with pH to produce complex outcomes. Calcium and magnesium ions, prevalent in hard water, can stabilize spore structures by binding to their outer layers, enhancing their resistance to heat and chemicals. However, high concentrations of heavy metals like copper or iron, even at parts per million levels, can catalyze oxidative damage to spore DNA and membranes. For example, water with 1 ppm of copper ions reduces *Clostridium botulinum* spore viability by 90% within 24 hours. Practical tip: When sterilizing water containing spores, consider using chelating agents like EDTA to neutralize heavy metals before treatment, ensuring more effective spore inactivation.
The interplay between pH and minerals creates a dynamic environment that can either preserve or destroy spores. In slightly acidic water (pH 5–6) with moderate mineral content, spores may enter a state of prolonged dormancy, delaying germination. This phenomenon is exploited in natural ecosystems, where spores survive in mineral-rich soils for decades. However, in highly alkaline, mineral-saturated water (pH 8–9 with high calcium), spores may mistakenly interpret the conditions as favorable for germination, only to be rapidly inactivated by osmotic stress. Caution: In industrial settings, such as canning or bottling, monitor both pH and mineral profiles to prevent false positives in sterilization tests, as spores may appear dormant but remain viable under certain conditions.
To manipulate spore behavior in water effectively, consider a two-pronged approach: pH adjustment and mineral management. For spore inactivation, maintain water at pH 3–4 using food-safe acids like citric or acetic acid, ensuring mineral concentrations are low to avoid protective binding. For spore preservation, stabilize water at pH 6–7 with buffering agents like phosphate, and include trace calcium (50–100 ppm) to reinforce spore coats without triggering germination. Comparative analysis reveals that while pH acts as the primary driver of spore response, minerals fine-tune the outcome, making their combined management indispensable for predictable results. Whether in a laboratory or a factory, mastering these chemical interactions empowers precise control over spore destiny in water.
Exploring Multicellular Spore Producers: Are They Diploid Organisms?
You may want to see also

Water Pressure Influence: Effects of hydrostatic pressure on spore activation and survival
Spores, the resilient survival structures of certain bacteria, fungi, and plants, exhibit remarkable adaptability to environmental stresses, including water pressure. Hydrostatic pressure, the force exerted by water at depth, significantly influences spore behavior, impacting both their activation and long-term survival. Understanding these effects is crucial for fields like microbiology, food safety, and astrobiology, where spores’ responses to pressure are pivotal.
Hydrostatic pressure can act as a double-edged sword for spores. On one hand, moderate pressure (up to 50 MPa) can stimulate spore germination, potentially by disrupting the spore’s protective layers and triggering metabolic reactivation. For instance, studies on *Bacillus subtilis* spores show increased germination rates at 20–30 MPa, mimicking conditions in deep-sea environments. This suggests that pressure could serve as a natural cue for spores to resume growth when conditions become favorable. Conversely, extreme pressures (above 100 MPa) often prove lethal, causing irreversible damage to spore structures, including DNA and protein denaturation.
To harness pressure’s activating potential, controlled environments like hyperbaric chambers can be employed. For laboratory experiments, exposing spores to 30–50 MPa for 30–60 minutes in a phosphate-buffered saline solution (pH 7.4) can induce germination in species like *Bacillus cereus*. However, caution is necessary: rapid pressure changes can shock spores, reducing viability. Gradual pressurization and depressurization over 10–15 minutes are recommended to minimize stress.
Comparatively, spores from different organisms respond uniquely to pressure. Marine-derived spores, such as those from *Bacillus* species found in ocean sediments, often tolerate higher pressures than terrestrial counterparts. For example, *Bacillus sporothermodurans* spores remain viable at pressures up to 800 MPa, showcasing evolutionary adaptations to deep-sea habitats. In contrast, plant spores, like those of ferns, are generally less pressure-tolerant, with viability declining sharply above 50 MPa.
Practically, understanding pressure’s role in spore survival has implications for food preservation and planetary exploration. High-pressure processing (HPP) at 400–600 MPa is increasingly used in the food industry to inactivate spores in products like juices and ready-to-eat meals, offering a non-thermal alternative to pasteurization. For astrobiologists, studying spores under extreme pressures mimics conditions on ocean worlds like Europa, where pressure-resistant spores could theoretically persist.
In conclusion, hydrostatic pressure is a critical factor in spore activation and survival, with effects ranging from stimulatory to lethal depending on intensity and organism. By applying controlled pressure regimes and studying species-specific responses, researchers can unlock new strategies for spore management, from food safety to extraterrestrial life detection. Whether in the lab or the deep sea, pressure’s influence on spores remains a fascinating and practical area of exploration.
Overriding Spore's Complexity Meter: Possibilities and Limitations Explained
You may want to see also
Frequently asked questions
Spores do not always germinate immediately in water. Germination depends on factors like temperature, nutrient availability, and the specific type of spore. Some spores require additional triggers, such as specific chemicals or environmental conditions, to initiate germination.
Yes, many spores can remain dormant in water for extended periods, sometimes years, without germinating. This dormancy is a survival mechanism that allows them to withstand harsh conditions until favorable conditions for growth are present.
Water temperature significantly influences spore behavior. Optimal temperatures can stimulate germination, while extreme temperatures (too hot or too cold) may inhibit it. Different spore species have specific temperature ranges that trigger or suppress their activity.





























